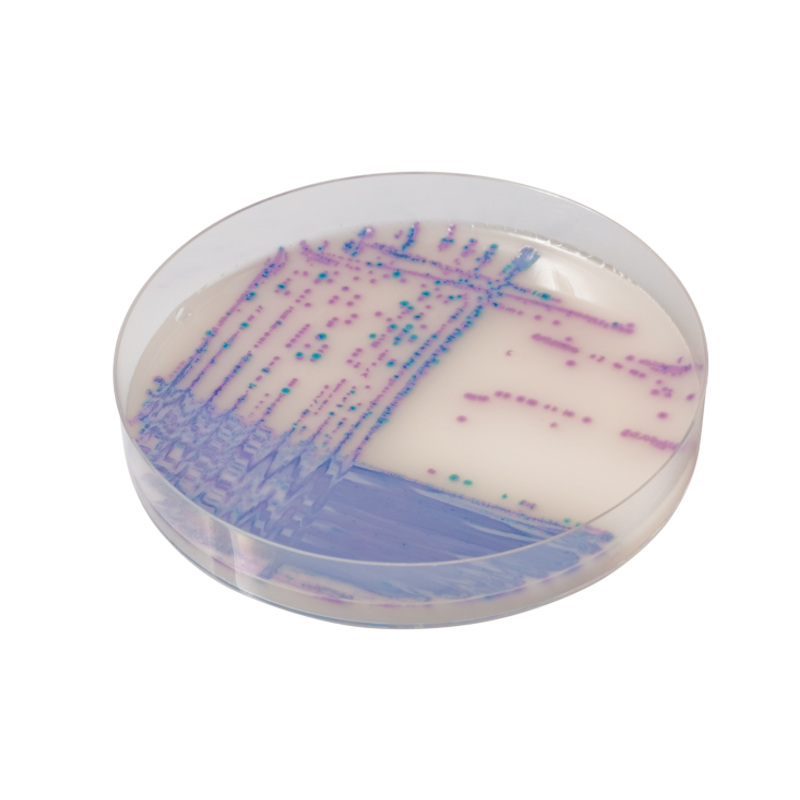
Sanimed -m CHROM Salmonella Plus

24930000-2 Фотохімікати
Назва категорії: Живильні середовищаОдиниці виміру: штука
Технічні характеристики
Вид
Відповідність ДСТУ EN ISO 11133:2014
Фасування
Основа складу
Знайдено: 253

Пептон лужний (основний) / ALKALINE PEPTONE, Sanimed-M

Sanimed -m CHROM StrepB

Агар Сабуро з глюкозою та хлорамфеніколом 50 мкг

Основа уреазного агару за Крістенсеном / CHRISTENSEN UREA AGAR BASE, Sanimed-M

Агар з бенгальським рожевим та хлорамфеніколом / Rose Bengal CAF agar, 250 г

КОЛУМБІЙСЬКИЙ КРОВ’ЯНИЙ АГАР з 5% баранячої крові COLUMBIA BLOOD AGAR with 5% Sheep Blood

Сольовий агар Sanimed-M

Сольовий агар з манітом/MANNITOL SALT AGAR, Sanimed -M

Середовище Гісса з манітом / GISSA AGAR W/ MANNITOL, Sanimed-M

Бульйон Фрейзера вторинного збагачення, 4014952+4240043
Sanimed -m CHROM Salmonella Plus
